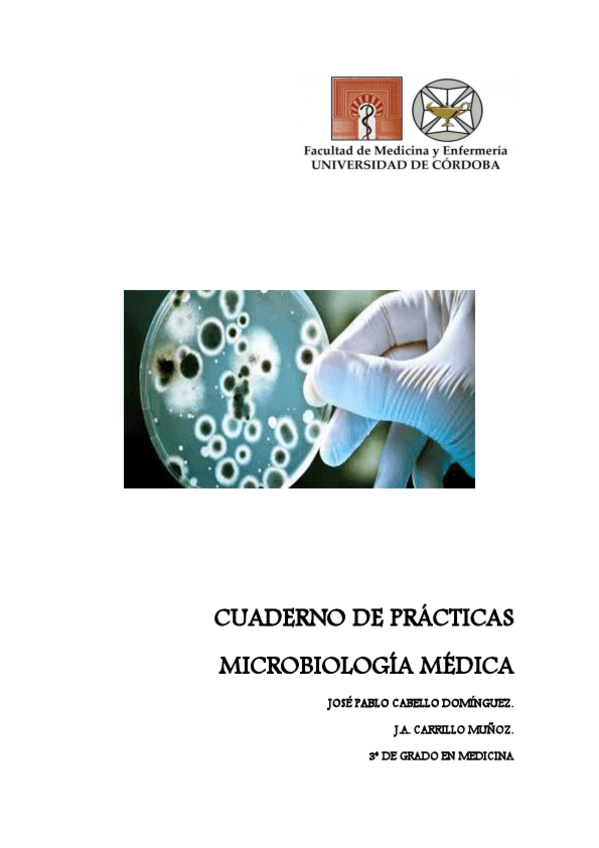

@CARRI3
Estudios: Grado en Medicina (UCO)
2 Publicaciones
525 Interacciones
0 Seguidores
1 Siguiendo
Lista de publicaciones de CARRI3
He publicado nuevos practicas de 3º Microbiología Médica y Enfermedades Infecciosas I: CUADERNO DE MICROBIOLOGÍA .pdf
He publicado nuevos practicas de 3º Microbiología Médica y Enfermedades Infecciosas I: CUADERNO DE MICROBIOLOGÍA.pdf